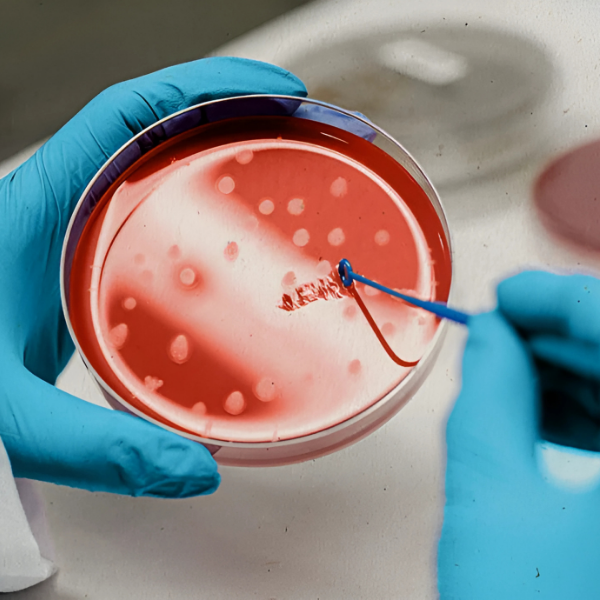

Our Services - Stem
Cell Treatment
What is Stem Cell Treatment?
Stem Cell Treatment in aesthetics and trichology uses the regenerative power of stem cell-derived growth factors to repair damaged tissues, stimulate hair follicles, and rejuvenate skin. It’s a cutting-edge, non-surgical therapy that harnesses the body’s natural healing response to restore volume, health, and vitality. At DAMSEL Dental & Aesthetic Clinic, we provide safe, clinically backed stem cell treatments for hair regrowth, skin rejuvenation, and anti-aging therapy using plant-based or autologous stem cell serums.
.png)
.png)
Stem Cell Therapy for Hair Regrowth
Stimulates dormant hair follicles and improves scalp circulation
Enhances hair density, strength, and quality
Suitable for both men and women with early to moderate hair loss
Works well in combination with PRP, GFC, or Mesotherapy
No downtime, minimal discomfort
Benefits of Stem Cell Treatment
Non-invasive & safe
Natural rejuvenation from within
No chemicals, surgery, or downtime
Long-lasting results with regular sessions
Enhances outcomes of other aesthetic procedures
Promotes tissue repair, hair follicle regeneration & anti-aging